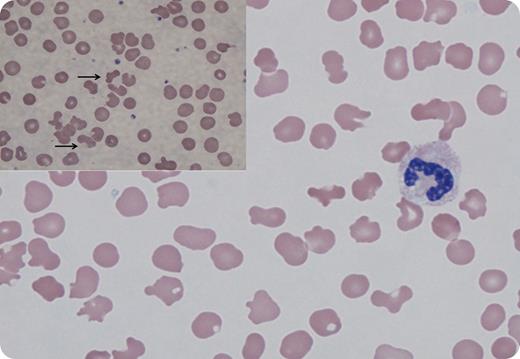
A 52-year-old man with untreated hepatitis C presented to the hospital with cough and shortness of breath. The examination was notable for ≥3 pitting edema, and cross-sectional imaging showed pleural effusions and ascites. Laboratory findings revealed a hemoglobin of 7.6 g/dL, creatinine 2.2 mg/dL, total protein 6.2 g/dL, albumin <1.5 g/dL, and an immunoglobulin M monoclonal paraprotein of 1940 mg/dL. Hepatitis C quantitation by polymerase chain reaction was >11 million IU/mL; bone marrow biopsy identified B-cell lymphoma with plasmacytic differentiation (MYD88 mutation negative). The patient then developed a rash of dusky violaceous plaques and macules. Out of concern for cryoglobulinemia, rheumatoid factor was checked and found to be elevated at >6000 IU/mL with an elevated cryocrit of 7% consistent with the diagnosis. A peripheral smear at room temperature was notable for distorted red cells, morphologically mimicking schistocytes and acanthocytes (Wright stain; original magnification ×1000). Haptoglobin, lactate dehydrogenase, fibrinogen, and routine coagulation tests were normal. At a different light refraction, smear revealed a marked background of cryoprecipitate (inset, arrows; Wright stain; original magnification ×1000), depositing on and deforming the red blood cell (RBC) membrane. / This case illustrates bizarre RBC morphologic changes in the presence of cryoglobulinemia with smear findings that raise concern for intravascular hemolysis. The patient’s available historical data, including a normal complete blood cell count and spleen size, make hereditary RBC structural disorders a highly unlikely cause of these findings.

A 52-year-old man with untreated hepatitis C presented to the hospital with cough and shortness of breath. The examination was notable for ≥3 pitting edema, and cross-sectional imaging showed pleural effusions and ascites. Laboratory findings revealed a hemoglobin of 7.6 g/dL, creatinine 2.2 mg/dL, total protein 6.2 g/dL, albumin <1.5 g/dL, and an immunoglobulin M monoclonal paraprotein of 1940 mg/dL. Hepatitis C quantitation by polymerase chain reaction was >11 million IU/mL; bone marrow biopsy identified B-cell lymphoma with plasmacytic differentiation (MYD88 mutation negative). The patient then developed a rash of dusky violaceous plaques and macules. Out of concern for cryoglobulinemia, rheumatoid factor was checked and found to be elevated at >6000 IU/mL with an elevated cryocrit of 7% consistent with the diagnosis. A peripheral smear at room temperature was notable for distorted red cells, morphologically mimicking schistocytes and acanthocytes (Wright stain; original magnification ×1000). Haptoglobin, lactate dehydrogenase, fibrinogen, and routine coagulation tests were normal. At a different light refraction, smear revealed a marked background of cryoprecipitate (inset, arrows; Wright stain; original magnification ×1000), depositing on and deforming the red blood cell (RBC) membrane.
This case illustrates bizarre RBC morphologic changes in the presence of cryoglobulinemia with smear findings that raise concern for intravascular hemolysis. The patient’s available historical data, including a normal complete blood cell count and spleen size, make hereditary RBC structural disorders a highly unlikely cause of these findings.
A 52-year-old man with untreated hepatitis C presented to the hospital with cough and shortness of breath. The examination was notable for ≥3 pitting edema, and cross-sectional imaging showed pleural effusions and ascites. Laboratory findings revealed a hemoglobin of 7.6 g/dL, creatinine 2.2 mg/dL, total protein 6.2 g/dL, albumin <1.5 g/dL, and an immunoglobulin M monoclonal paraprotein of 1940 mg/dL. Hepatitis C quantitation by polymerase chain reaction was >11 million IU/mL; bone marrow biopsy identified B-cell lymphoma with plasmacytic differentiation (MYD88 mutation negative). The patient then developed a rash of dusky violaceous plaques and macules. Out of concern for cryoglobulinemia, rheumatoid factor was checked and found to be elevated at >6000 IU/mL with an elevated cryocrit of 7% consistent with the diagnosis. A peripheral smear at room temperature was notable for distorted red cells, morphologically mimicking schistocytes and acanthocytes (Wright stain; original magnification ×1000). Haptoglobin, lactate dehydrogenase, fibrinogen, and routine coagulation tests were normal. At a different light refraction, smear revealed a marked background of cryoprecipitate (inset, arrows; Wright stain; original magnification ×1000), depositing on and deforming the red blood cell (RBC) membrane.
This case illustrates bizarre RBC morphologic changes in the presence of cryoglobulinemia with smear findings that raise concern for intravascular hemolysis. The patient’s available historical data, including a normal complete blood cell count and spleen size, make hereditary RBC structural disorders a highly unlikely cause of these findings.
For additional images, visit the ASH Image Bank, a reference and teaching tool that is continually updated with new atlas and case study images. For more information, visit http://imagebank.hematology.org.